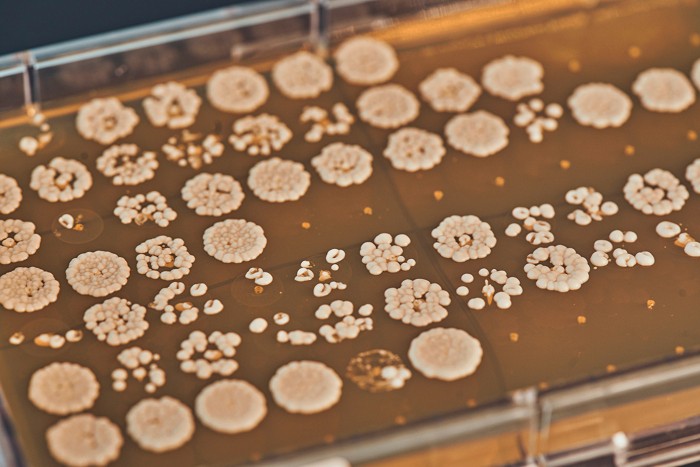
An orange tray growing a grid of white microbial cultures.

Advertisement
Grab your lab coat. Let's get started
Welcome!
Welcome!
Create an account below to get 6 C&EN articles per month, receive newsletters and more - all free.
It seems this is your first time logging in online. Please enter the following information to continue.
As an ACS member you automatically get access to this site. All we need is few more details to create your reading experience.
Not you? Sign in with a different account.
Not you? Sign in with a different account.
ERROR 1
ERROR 1
ERROR 2
ERROR 2
ERROR 2
ERROR 2
ERROR 2
Password and Confirm password must match.
If you have an ACS member number, please enter it here so we can link this account to your membership. (optional)
ERROR 2
ACS values your privacy. By submitting your information, you are gaining access to C&EN and subscribing to our weekly newsletter. We use the information you provide to make your reading experience better, and we will never sell your data to third party members.
Biobased Chemicals
Biomanufacturing isn’t cleaning up chemicals
Synthetic biology firms promised a low-carbon industry, but so far they haven’t delivered
by Matt Blois
April 22, 2024
| A version of this story appeared in
Volume 102, Issue 12

Credit: Shutterstock/C&EN
In brief
Biomanufacturing firms have long promised that engineering microbes to convert biomass into chemicals would reduce the chemical industry’s carbon footprint. So far, these companies have produced small volumes of high-value chemicals, not the commodities that represent most of the industry’s emissions. After decades of work, these efforts have barely made a dent in the nearly 1 billion metric tons of greenhouse gases released by the chemical industry each year. But biomanufacturing companies still say they can help abate those emissions. Some claim that biobased chemicals’ climate benefits will accumulate as the tally of facilities increases. Others say new technologies that ferment cheap waste into chemicals will be needed to compete with petrochemicals. Skeptics argue that sustainable chemicals won’t displace chemicals made from fossil fuels unless policies force chemical firms to account for the environmental costs of their emissions.
In summer 2008, US crude oil prices reached an all-time high. And so did the ambitions of companies that hoped they could replace oil refineries and chemical plants with microbes genetically engineered to ferment sugar into plastics, fuels, and myriad other products.
These firms argued that making chemicals this way, an approach often labeled synthetic biology, would slash the chemical industry’s greenhouse gas emissions and wean the world off fossil fuels. Investors bought in, pouring millions of dollars into sustainable chemical companies like Solazyme, LS9, and Amyris.
“People were talking about peak oil and were convinced that the price of oil was never going to go back down. . . . The economics were all going to play out in our favor,” recalls Joel Cherry, who was Amyris’s president of R&D from 2008 to 2019. “That didn’t happen.”
As the financial crisis worsened through 2008, oil prices plunged. Biomanufacturing start-ups struggled to compete with petrochemical giants. Some firms survived by pivoting to high-value molecules for pharmaceuticals, cosmetics, or food, but many failed. Today, biobased plastics account for less than 1% of global production of plastic, according to the trade group European Bioplastics.
In the push toward a carbon-neutral economy, the chemical industry remains one of the biggest challenges. In 2022, making basic chemicals produced the equivalent of almost 1 billion metric tons (t) of carbon dioxide, according to the International Energy Agency; producing chemicals from sugar instead of oil has barely made a dent in those emissions.
Now synthetic biology firms are again making bold claims about replacing petrochemicals and abating emissions in the process. Some companies say incremental improvements to microbial strains and fermentation processes will enable firms to gradually move from high-value products into the commodities that account for most of the chemical industry’s emissions. Others are developing microbes that ferment inexpensive waste, like agricultural residues, municipal waste, and industrial gases.
But will this renewed enthusiasm for synthetic biology yield a different result? While biomanufacturing companies have already found niches for some expensive products, doubters say it might take decades before fermentation-derived molecules are cheap enough to replace oil-derived commodities. And they warn that without policies forcing the petrochemical industry to account for the health and environmental costs of its carbon emissions, fermentation may never displace fossil fuels.
“There is long-term potential for us to have our chemicals produced through fermentation,” says Kristin Marshall, a chemical industry analyst with the intelligence firm Lux Research. “But until those incentives are there to help make the economics make sense, I don’t think it’s going to be possible.”
Fermentation’s graveyard
The synthetic biology company graveyard is crowded.
Here lies LS9, a biofuel company that was valued at $200 million in 2011 and sold for $62 million in 2014. Here lies BioAmber, which launched in 2008 to make polymers from biobased succinic acid and went bankrupt in 2018 when few customers materialized. Here lies Zymergen, a buzzy start-up that was acquired by a competitor in 2022 after its first product flopped.
Add to that list Amyris, which went bankrupt last summer.
The firm was founded in 2003 by a group of scientists from the University of California, Berkeley, and soon after received a grant from the Bill and Melinda Gates Foundation to engineer, on a nonprofit basis, microbes that make an isoprenoid precursor for the antimalarial drug artemisinin.
As the artemisinin project progressed, Amyris began looking for new isoprenoids to sell, this time for a profit. The company’s founders first pitched molecules like flavors and fragrances, but cofounder Jack Newman says investors were more enthusiastic about the huge financial opportunity in fuels.
Amyris raised $20 million from venture capital investors (VCs) in 2006 and promised to make farnesene, which could be converted into a replacement for diesel or jet fuel. “The argument from the VCs was, Why not just go for the home run?” Newman says.
Big gap

At that time, the company’s microbes were converting a tiny fraction of the sugar they were fed into farnesene. Amyris leaders assured the company’s scientists that boosting yields to 90% of the metabolic pathway’s theoretical maximum—on par with ethanol production—would make the process cheap enough to compete in the fuel market, according to Tim Gardner, who worked on Amyris’s fermentation technology between 2007 and 2014.
Former Amyris employees describe this project with the nostalgia of high school football players reminiscing about the time they won the state championship. Cherry says scientists often worked 7 days a week. “It was the biological equivalent of trying to break the sound barrier,” Gardner says. “It was total belief. Total excitement. Total focus. . . . The problem was that it was predicated on a false promise.”
Gardner claims that even after Amyris’s R&D team engineered a new, more efficient metabolic pathway to farnesene, production costs were still too high. By 2011, he told Amyris leaders that he didn’t think the technology would ever achieve the company’s overly ambitious cost targets. Frustrated by the decision to keep chasing biofuels, Gardner left Amyris in 2014.
“They were struggling to close a massive gap between investor expectations and biological, physical reality,” he says.
Not everyone felt the same way. Sunil Chandran, an early Amyris employee who eventually became chief science officer, acknowledges that Amyris overpromised, like most Silicon Valley start-ups do. But he maintains that many of the company’s scientists believed it was possible to make biofuels economically.
Newman agrees. The scientific challenge was enormous, he says, but Amyris was making a reasonable bet. “The upside, should you win at fuels, is so great that you’re willing to take a high degree of risk,” he says.
The price of oil remained low through Amyris’s intense sprint to boost yield, falling more than 60% from the summer of 2008 to the end of 2014. During these years, Amyris continued to pursue biofuels but increasingly emphasized nonfuel products such as fragrances, vitamins, and the moisturizer squalane. In 2015, Amyris started decreasing unprofitable biofuel production to focus almost entirely on higher-value molecules.
Gardner says the shift came too late. At that point, Amyris had spent years developing a fermentation process focused on fuels, and investors had given the company nearly $1 billion to create a behemoth business using that technology. Gardner says the prolonged and expensive fuel project drained Amyris’s resources and made it difficult for the company to transition to a more modest vision focused on low-volume molecules.
“That sustainable business model is never grand enough for all the money those investors have put in,” he says. “That’s what did them in.”
Start small
For firms that survived the biofuel era, and start-ups that have emerged since then, the demise of Amyris and its competitors offers a lesson: start small or die. Instead of commodities, these companies are first targeting molecules that command a higher margin. They hope that approach will give them time to develop processes efficient enough for larger markets that offer slimmer margins.
Scott Franklin, cofounder and chief scientific officer of the biomanufacturing firm Checkerspot, learned about the dangers of aiming for big markets before a technology is ready when he worked at Solazyme, a biofuel maker that went bankrupt in 2017. He believes that synthetic biology’s path to climate benefits will be a series of small steps forward, the same way the oil and gas industry gradually became superefficient.
Petrochemical plants have a 100-year head start on most fermentation plants, but Franklin predicts that sustainable chemical manufacturing will catch up. “The room for optimization is really vast,” he says.

Checkerspot uses microalgae to ferment sugar into triglycerides and then chemically converts them into a polyol. The company uses the polyols to make urethanes, polymers, or other chemicals that it puts into its own brand of skis, snowboards, and clothing.
Franklin says bigger markets might open up over time, but he’s in no rush. His strategy for maximizing the company’s reduction of greenhouse gas emissions is to stay in business long enough to benefit from the accumulation of fermentation improvements.
“It is the steady, incremental progress that wins,” he says. “It’s a marathon.”
In 2006, Amyris pitched itself as a sprinter rather than a marathoner. Gardner says that helped the company raise huge amounts of funding. The quick returns didn’t materialize, but he says the money spent on fuel research enabled the company to successfully commercialize several specialty chemicals with smaller markets.
For example, Checkerspot combines its polyurethanes with a biobased replacement for polybutadiene developed by a joint venture between Amyris and the oil firm TotalEnergies. And 70% of the squalane used in personal care products now comes from a fermentation process Amyris developed rather than from shark livers.
Amyris could have turned those achievements into a small, successful business, Gardner says. “But it was always pursuing these big dreams that were beyond what was achievable.”
Amyris now has another chance to reinvent itself, and this time it’s taking a slow and steady approach. In court filings, Amyris has proposed a plan, dubbed Amyris 2.0, to emerge from bankruptcy as a company focused on cosmetic and beauty ingredients, both existing products and new molecules in development, which would be manufactured primarily at the fermentation plant Amyris still owns in Brazil.
Before entering bankruptcy, Amyris owned 10 unprofitable consumer brands, as well as its own influencer marketing company. Under the 2.0 plan, Amyris would do away with all direct-to-customer sales and exclusively sell ingredients to other companies. The company is working with the investment firm Foris Ventures to secure a $160 million loan to revive the business. Amyris is also renegotiating contracts with its key customers, DSM-Firmenich and Givaudan, as it prepares to emerge from bankruptcy.
In addition to selling its own ingredients, Amyris would also license its technology and work with other firms to create fermentation processes for molecules they want to use or sell. Newman, who is no longer involved with Amyris, says the company’s R&D team will be its strength. “A good portion of the technologists are still intact,” he says. “They’re still going to move forward.”
Chipping away
Progress is slow, but the tally of facilities producing chemicals via fermentation is increasing. Some biomanufacturing leaders say the best way to lower the chemical industry’s carbon footprint is to simply keep building these facilities. The benefit, they say, will add up over time.
Genomatica has been one of the most successful firms establishing such plants. The company’s joint venture with Unilever, Kao, and L’Oréal recently demonstrated 63,000 L fermentation runs for personal care and cleaning product ingredients that are normally made from palm oil. Genomatica is also working with Aquafil to scale up the fermentation of nylon precursors at a facility in Slovenia.

But the company’s biggest success is biobased 1,4-butanediol (BDO), a chemical used to make spandex and other polymers. Since 2016, Novamont has been using Genomatica’s technology at a plant in Italy that can make 30,000 t of BDO per year.
Advertisement
Qore, a joint venture between Cargill and Helm, will use the technology at a $300 million plant it’s building in Iowa that will make 66,000 t of BDO per year when it opens in 2025. And in March, Genomatica announced that Hyosung TNC plans to use the process at a $1 billion facility in Vietnam intended to make 50,000 t of BDO annually by 2026 and up to 200,000 t annually by 2035.
As the number and scale of these plants increase, their collective capacity to reduce carbon emissions will rise, Genomatica CEO Christophe Schilling says. “You’re going to chip away because there’ll be more and more plants,” he says. “You’re going to start doing the math, and . . . these are big, big numbers.”
If the material produced at Qore’s plant replaces BDO made from coal, the process typically used in China, the plant could avert a little more than 1 million t of CO2emissions each year, according to the company’s life-cycle analysis. That’s equivalent to the annual emissions from about 3 of the 2,000 natural gas–fired power plants in the US.

Outside China, though, BDO is usually made from a natural gas-based process, which has a much lower carbon footprint than the coal-based route. Replacing a natural gas process would not cut emissions nearly as much—less than 250,000 t of CO2 at the scale of Qore’s plant.
Marshall, the Lux Research analyst, says focusing on BDO or nylon precursors is a good strategy because markets already exist, and biomanufacturers don’t have to convince customers to adopt new materials. Consumers might also be willing to pay a premium for clothing or shoes made with these products. But the polymers in yoga pants and shoe soles account for only a sliver of what the petrochemical industry churns out.
“Maybe this is something you could target . . . to help a company decarbonize,” Marshall says. “It’s not going to tip the needle in terms of decarbonizing the chemical industry.”
According to the consulting firm McKinsey, chemical companies already have access to technologies, such as recycling and improvements to energy efficiency, that could cut about one-third of their expected emissions by 2030, but they will need additional tools to tackle the remainder. Right now, the firm doesn’t expect synthetic biology to offer much help in the near term.
McKinsey analyst Tom Brennan says biobased chemical firms won’t meaningfully reduce CO2 emissions unless they build a lot more plants. But many projects fizzle in the R&D stage because the economics don’t work out.
Tire makers like Goodyear Tire & Rubber and Michelin have repeatedly tried to replace synthetic rubber components using fermentation but haven’t developed a cheap enough substitute. For years, firms like Procter & Gamble, LG Chem, and Cargill have pursued various routes to a biobased version of acrylic acid, used to make superabsorbent polymers for diapers. All have been too expensive to commercialize.
An analysis from the consulting firm Deloitte found that just 10 building blocks, including ammonia, methanol, ethylene, and propylene, account for 70% of the chemical industry’s emissions. But fermentation has barely touched them.
“It’s hard for biomaterials to change the structure of an industry,” Brennan says.
Aim high
Some synthetic biology leaders see the long list of failed biochemical projects as proof that sugar is too expensive a starting material for large-volume chemicals. Instead, they want to develop microbes that can convert cheap sources of waste into the handful of commodity chemicals that make up the vast majority of emissions.
Feeding sugar to yeast can be a good way to make expensive pharmaceutical ingredients, but Sarah Richardson, CEO of the start-up MicroByre, says this approach quickly hits a limit as volumes increase and profit margins get tighter. She says the solution is to switch to the mountains of biomass not found in a farmer’s field: seaweed, cow poop, and food waste. “If it rots, something’s eating it,” she says.

Baker’s yeast and Escherichia coli, the organisms typically used in biomanufacturing processes, don’t thrive on this type of food, so Richardson argues that companies should use less common microbes. There’s typically less information about how to engineer these organisms or how to make them grow in a bioreactor. MicroByre is cataloging the bacteria growing on waste biomass and the molecules they produce naturally.
“Where is the organism . . . that’s going to eat a waste feedstock and produce a meaningful chemical?” Richardson asks. “And happily, its whole purpose of existing is to make this chemical, so I don’t have to do a lot of risky engineering.”
The synthetic biology firm LanzaTech is trying to make chemicals from another source of waste: the gases sent up the stacks of industrial plants. The company engineers Clostridium autoethanogenum—a bacterium that naturally consumes carbon monoxide and hydrogen for energy—to turn emissions from steel mills, ferroalloy mills, and oil refineries into ethanol, which the company can use to make jet fuel and other chemicals.
LanzaTech is also working on bacteria strains that can directly produce commodity chemicals like acetone, isopropyl alcohol, and ethylene glycol without going through ethanol as an intermediate step. Skipping chemical conversion steps would reduce energy use and costs, Chief Science Officer Zara Summers says.
Robert Kumpf, a chemical industry analyst at Deloitte, says using synthetic biology to make the chemical industry’s basic building blocks would be a huge step forward because it would also allow chemical firms to use billions of dollars of existing infrastructure to transform low-carbon intermediates into thousands of other chemicals. “That infrastructure exists. We need it,” he says.
There isn’t enough carbon coming out of steel mills to replace all petrochemicals, so Summers says LanzaTech is tuning its microbes to thrive on a variety of feedstocks. In Japan, Sekisui Chemical built a demonstration plant with LanzaTech’s technology to make ethanol using gasified municipal solid waste. In Canada, Suncor Energy is employing the technology to turn gasified forestry residues into ethanol. “There are feedstocks everywhere,” Summers says.
Waste feedstocks have potential, but biotechnology consultant Steve Weiss points out that companies have struggled to execute these approaches. So far, nearly all successful biobased chemical projects have used sugar, and he says it makes sense to keep going down that road. “Deploy the things that enable working solutions now,” Weiss says. “If, when, and where these other technologies are viable, fantastic, bolt those on.”
Richardson finds this line of thinking infuriating. She says the need to eliminate emissions from the chemical industry is so urgent that it doesn’t make sense to aim for incremental progress. Echoing the boldness of firms like Amyris, she says the threat of climate change requires taking big risks. “Why aren’t we swinging for the fences?” she says. “We don’t have time.”
Pipe dream
Better technologies and feedstocks will make sustainable chemicals cheaper, but many industry leaders acknowledge that transitioning the industry away from fossil fuels entirely may also require policies that bake the environmental cost of greenhouse gas emissions into products made from oil. Others argue that synthetic biology is the wrong tool for making large volumes of chemicals and that the technology will reduce emissions more significantly outside the chemical industry.
The International Monetary Fund estimates that the fossil fuel industry is effectively supported by $7 trillion in subsidies per year, which come largely in the form of government spending to deal with petroleum’s negative impacts. If oil and chemical companies had to price the cost of hurricane recovery, wildfire pollution, and heat-related deaths into their products, Genomatica’s Schilling says, the adoption of biobased chemicals would skyrocket.
“The only way that it’s really going to go big is if there’s a price on carbon,” he says. “We’re kind of a ways away from that.”
Chandran, Amyris’s former chief science officer, says that without government support or major technological improvements, synthetic biology companies should focus on developing specialized chemicals to boost the performance of technologies that mitigate climate change more directly. For example, they can create enzymes that help detergents clean with cold water.
In 2023, Chandran left Amyris to become the chief science officer at Impossible Foods, which uses fermentation to produce heme, the molecule that makes Impossible’s plant-based burgers taste like meat. “How do you reduce emissions from meat consumption? By giving consumers a better choice,” he says.
Nearly 2 decades after Amyris started pitching investors the idea that fermentation vats could replace petrochemical plants, virtually all chemicals are still made from fossil fuels. Cherry, Amyris’s former president of R&D, is optimistic that synthetic biology can make the chemical industry more sustainable. Over the next decade, he expects scientific advances will make it easier to coax microbes into producing all kinds of things.
Advertisement
Still, he says companies making commodities via fermentation will struggle to beat petrochemical firms that have had a century to optimize every valve, gasket, and filter. “Asking for synthetic biology to compete with an industry like that, right from the start, is just not realistic,” he says.
Fermentation may be an expensive way to make chemicals, but Cherry points out that carbon emissions are costly too. Governments already spend billions of dollars each year to mitigate the effects of climate change. One way or another, he says, “you’ve got to pay for the carbon.”





Join the conversation
Contact the reporter
Submit a Letter to the Editor for publication
Engage with us on Twitter